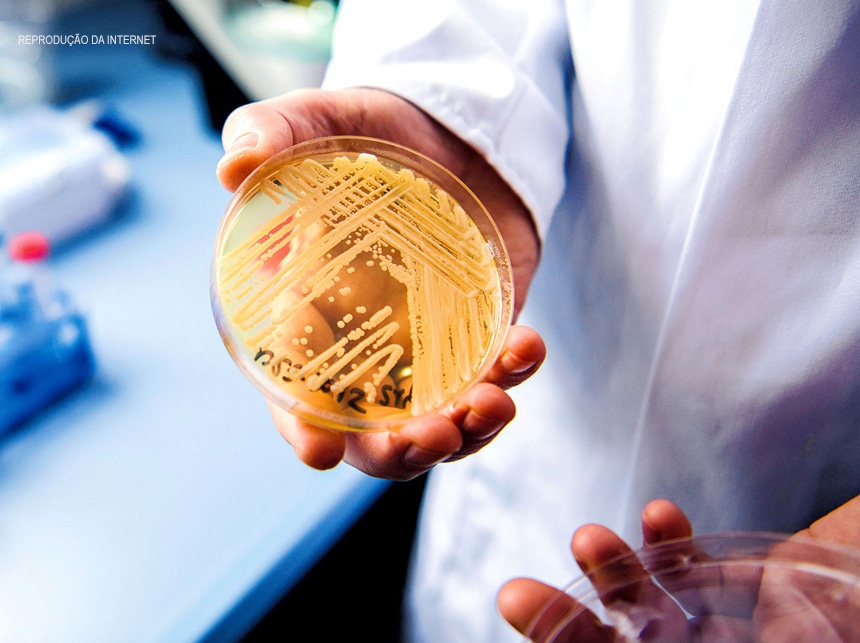
Superfungo no Brasil: Anvisa publica alerta de risco após confirmar caso de Candida auris

Por Jonas Valente
O número de médicos cresceu fortemente nos últimos anos no Brasil, atingindo mais de 500 mil profissionais, uma média de 2,4 para cada 1 mil habitantes. Entretanto, a distribuição ainda é bastante desigual, com maior presença nas regiões mais ricas e menos oferta no Norte e Nordeste.
Os dados estão em pesquisa lançada hoje (8) pelo Conselho Federal de Medicina. O levantamento da demografia médica brasileira foi elaborado por pesquisadores da Faculdade de Medicina da Universidade de São Paulo e chegou a sua 5ª edição, avaliando a evolução dos profissionais desta carreira.
Entre 2010 e 2020, o país ganhou 180 mil novos médicos. A taxa de aumento do número desses profissionais foi maior do que de crescimento da população em geral, ampliando o indicador de 1,7 para 2,4 por 1 mil habitantes nos últimos 10 anos.
Em entrevista coletiva virtual para a divulgação do estudo, o autor, professor Mário Scheffer, destacou que o Brasil galgou espaços no ranking internacional. Nesta última edição do levantamento, quando considerada a média por 1 mil habitantes o país ficou à frente de outras nações como México, Japão, Coreia do Sul e Colômbia.
Contudo, o país ainda está abaixo da média dos países da Organização para a Cooperação e Desenvolvimento Econômico (OCDE), que é de 3,4 para cada 1 mil habitantes. O Brasil vem atuando para ser admitido no grupo.

Mário Scheffer avaliou que o aumento do número de médicos no Brasil é decorrente da ampliação da estrutura de oferta no ensino superior para esta área, que ocorreu por meio da liberação de novos cursos nos últimos anos.
“Aumentou em função da abertura desenfreada de cursos e expansão de vagas em escolas que já existiam. De 2011 até agora foram mais de 20 mil novas vagas de graduação de medicina. É isso que impacta no número de médicos. Temos quase 37,8 mil vagas em 2020.
Entre 2010 e 2020, a média de profissionais que deixaram a carreira a cada ano ficou estável entre 1,2 mil e 1,5 mil. Contudo, o número de egressos dos cursos de medicina anualmente foi de 12,7 mil para 21,9 mil neste período. Segundo o presidente do Conselho Federal de Medicina Mauro Ribeiro, diante do grande número de egressos, a cada ano há deficiência para poder dar continuidade à formação adequada. “Não existe infraestrutura hospitalar que permita aumento de vagas de residência para acompanhar este aumento exponencial de formandos no Brasil”, pontuou.
Desigualdade
Mas o estudo também verificou que apesar do incremento na oferta de médicos, esta está distribuída de forma desigual no território brasileiro. Nas regiões Sul e Sudeste e em estados mais ricos ou com produto interno bruto per capita mais alto, como São Paulo, Rio de Janeiro ou Distrito Federal, possuem taxas muito maiores do que os demais. No Sudeste a proporção médico/habitante é de 3,15 e na Sul, 2.68. Na capital, a média é de 5,11.
Já no Norte e Nordeste o quadro é bem diferente, com taxas respectivas de 1,3 e 1,69 profissionais para cada 1 mil habitantes. O Pará, por exemplo, possui a menor média, de 1,07 médicos para cada 1 mil habitantes, cerca de cinco vezes menos do que a capital do país.
Na comparação entre capitais e interior, também se verifica desigualdade. Enquanto as cidades do interior abrigam 76,2% da população, elas possuem apenas 45,7% dos médicos. E o crescimento tem sido lento: em 2017 eram 44,9% profissionais desta carreira. Já as capitais são local de residência de 23,8% dos brasileiros mas contam com 54,3% dos formados em medicina.
“Foi feita uma política de abertura de escolas médicas com justificativa de que aumentaria a oferta. Alertamos que tinha que ter política pública de indução da ida do médico para o interior. Esta desigualdade persiste não obstante o aumento absurdo de escolas médicas”, avaliou Mauro Ribeiro.
A falta de equilíbrio ocorre também quando comparados os sistemas de saúde. Dos profissionais, 28% atendem exclusivamente no setor privado, 22% somente no setor público e os 50% restantes nos dois tipos de serviços.
“Como num país de meio milhão de médicos pode haver escassez de profissionais? Além da desigualdade na distribuição regional há também dentro do próprio sistema de saúde. Se pensarmos que o setor privado atende 25% da população, temos concentração de médicos de forma desproporcional, muito mais concentrados nas estruturas privadas de saúde”, analisou Mário Scheffer.
Perfil demográfico
O estudo também verificou o perfil demográfico a profissão. Nas últimas duas décadas, houve um acréscimo na proporção de mulheres. Se em 1990 elas representavam 31% dos profissionais, em 2020 chegaram a 47%. Em 2019, 57,5% dos novos registros dos conselhos regionais de medicina eram dados a médicas, enquanto 42,5%, a médicos.
Com a abertura de novos cursos e entrada de mais pessoas por ano, a idade média caiu, chegando a 45 anos em 2020. Por conta do incremento de mulheres na carreira, estas possuem uma média de idade menor, de 42 anos. Já no caso dos homens este índice é maior, de 48 anos.